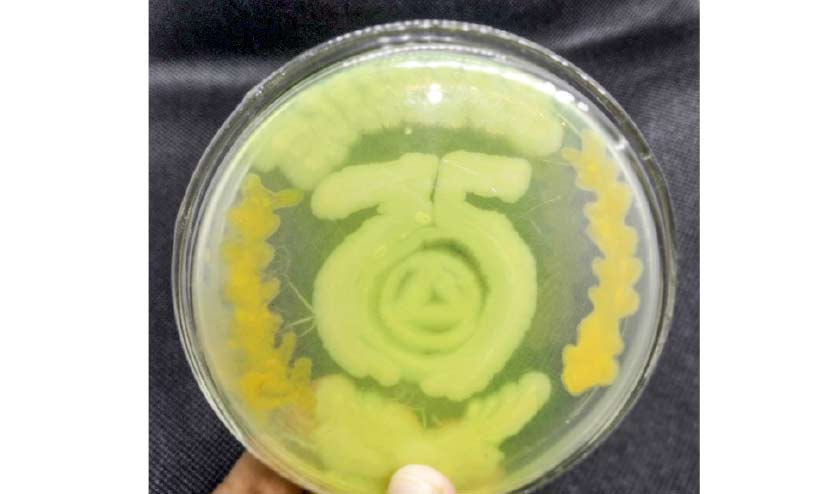

അഗാർ ആർട്ട്: പ്ലാറ്റിനം ജൂബിലി വർഷത്തിൽ എസ്.ഡി കോളജിന് വ്യത്യസ്ത ആദരമൊരുക്കി ബോട്ടണി വിഭാഗം
text_fieldsആലപ്പുഴ: പ്ലാറ്റിനം ജൂബിലി ആഘോഷിക്കുന്ന ആലപ്പുഴ എസ്.ഡി കോളജിെൻറ ജൂബിലി ലോഗോ മിത്ര ബാക്ടീരിയകളെ ഉപയോഗിച്ച് ഒരുക്കി വ്യത്യസ്തത തീർത്ത ബോട്ടണി ഗവേഷണ വിഭാഗത്തിെൻറ ശ്രമം കൗതുകമാകുന്നു. സ്ഫടികംകൊണ്ട് നിർമിച്ച പെട്രി പ്ലേറ്റുകളിൽ സ്യൂഡോമൊണാസ്, സാന്തോ മൊണാസ്, എൻററോ ബാക്ടർ എന്നിങ്ങനെ മൂന്ന് വ്യത്യസ്ത ബാക്ടീരിയകളെ ലോഗോ രൂപത്തിൽ അതീവ ശ്രദ്ധയോടെയും ക്ഷമയോടെയുമാണ് വളർത്തിയെടുത്തത്.
സാധാരണ ഇങ്ങനെയുള്ള ബാക്ടീരിയകളെ പ്ലേറ്റിൽ വളത്തുമ്പോൾ മറ്റ് ഫംഗസുകളും ബാക്ടീരിയകളും ഇതോടൊപ്പം കടന്നുകൂടാനുള്ള സാധ്യത ഏറെയാണ്. 'മൈക്രോബയോളജി ആർട്ട്' അഥവാ 'അഗാർ ആർട്ട്' എന്ന ഈ കലാരൂപത്തിലൂടെ മുമ്പുതന്നെ പുതുവത്സര ആശംസകൾ ബാക്ടീരിയകളെ പ്ലേറ്റിൽ വളർത്തി പ്രതിഭ തെളിയിച്ച ഗവേഷണ വിദ്യാർഥി ടി.എസ്. രേഷ്മയാണ് ലോഗോ നിർമിതി നടത്തിയത്.
ബോട്ടണി ഗവേഷണ വിഭാഗം മേധാവി ഡോ. സി. ദിലീപിെൻറ കീഴിലാണ് ഗവേഷണം പുരോഗമിക്കുന്നത്. യൂറോപ്പിലും മറ്റും വിവാഹ-പിറന്നാൾ സമ്മാനമായി ഇത്തരം അഗാർ ആർട്ട് വസ്തുക്കൾ നൽകുക പതിവുണ്ടെന്ന് ഡോ. ദിലീപ് 'മാധ്യമ'ത്തോട് പറഞ്ഞു. 24 മുതൽ പരമാവധി 48 മണിക്കൂർ വരെ മാത്രമേ ഇത് ഭംഗിയോടെ നിലനിൽക്കുകയുള്ളൂവെങ്കിലും അതിനുപിന്നിലെ ശ്രമകരമായ അധ്വാനം മുൻനിർത്തി പ്രത്യേകത നിറഞ്ഞ ഒന്നായാണ് കണക്കാക്കുന്നതെന്ന് അദ്ദേഹം കൂട്ടിച്ചേർത്തു.
Don't miss the exclusive news, Stay updated
Subscribe to our Newsletter
By subscribing you agree to our Terms & Conditions.